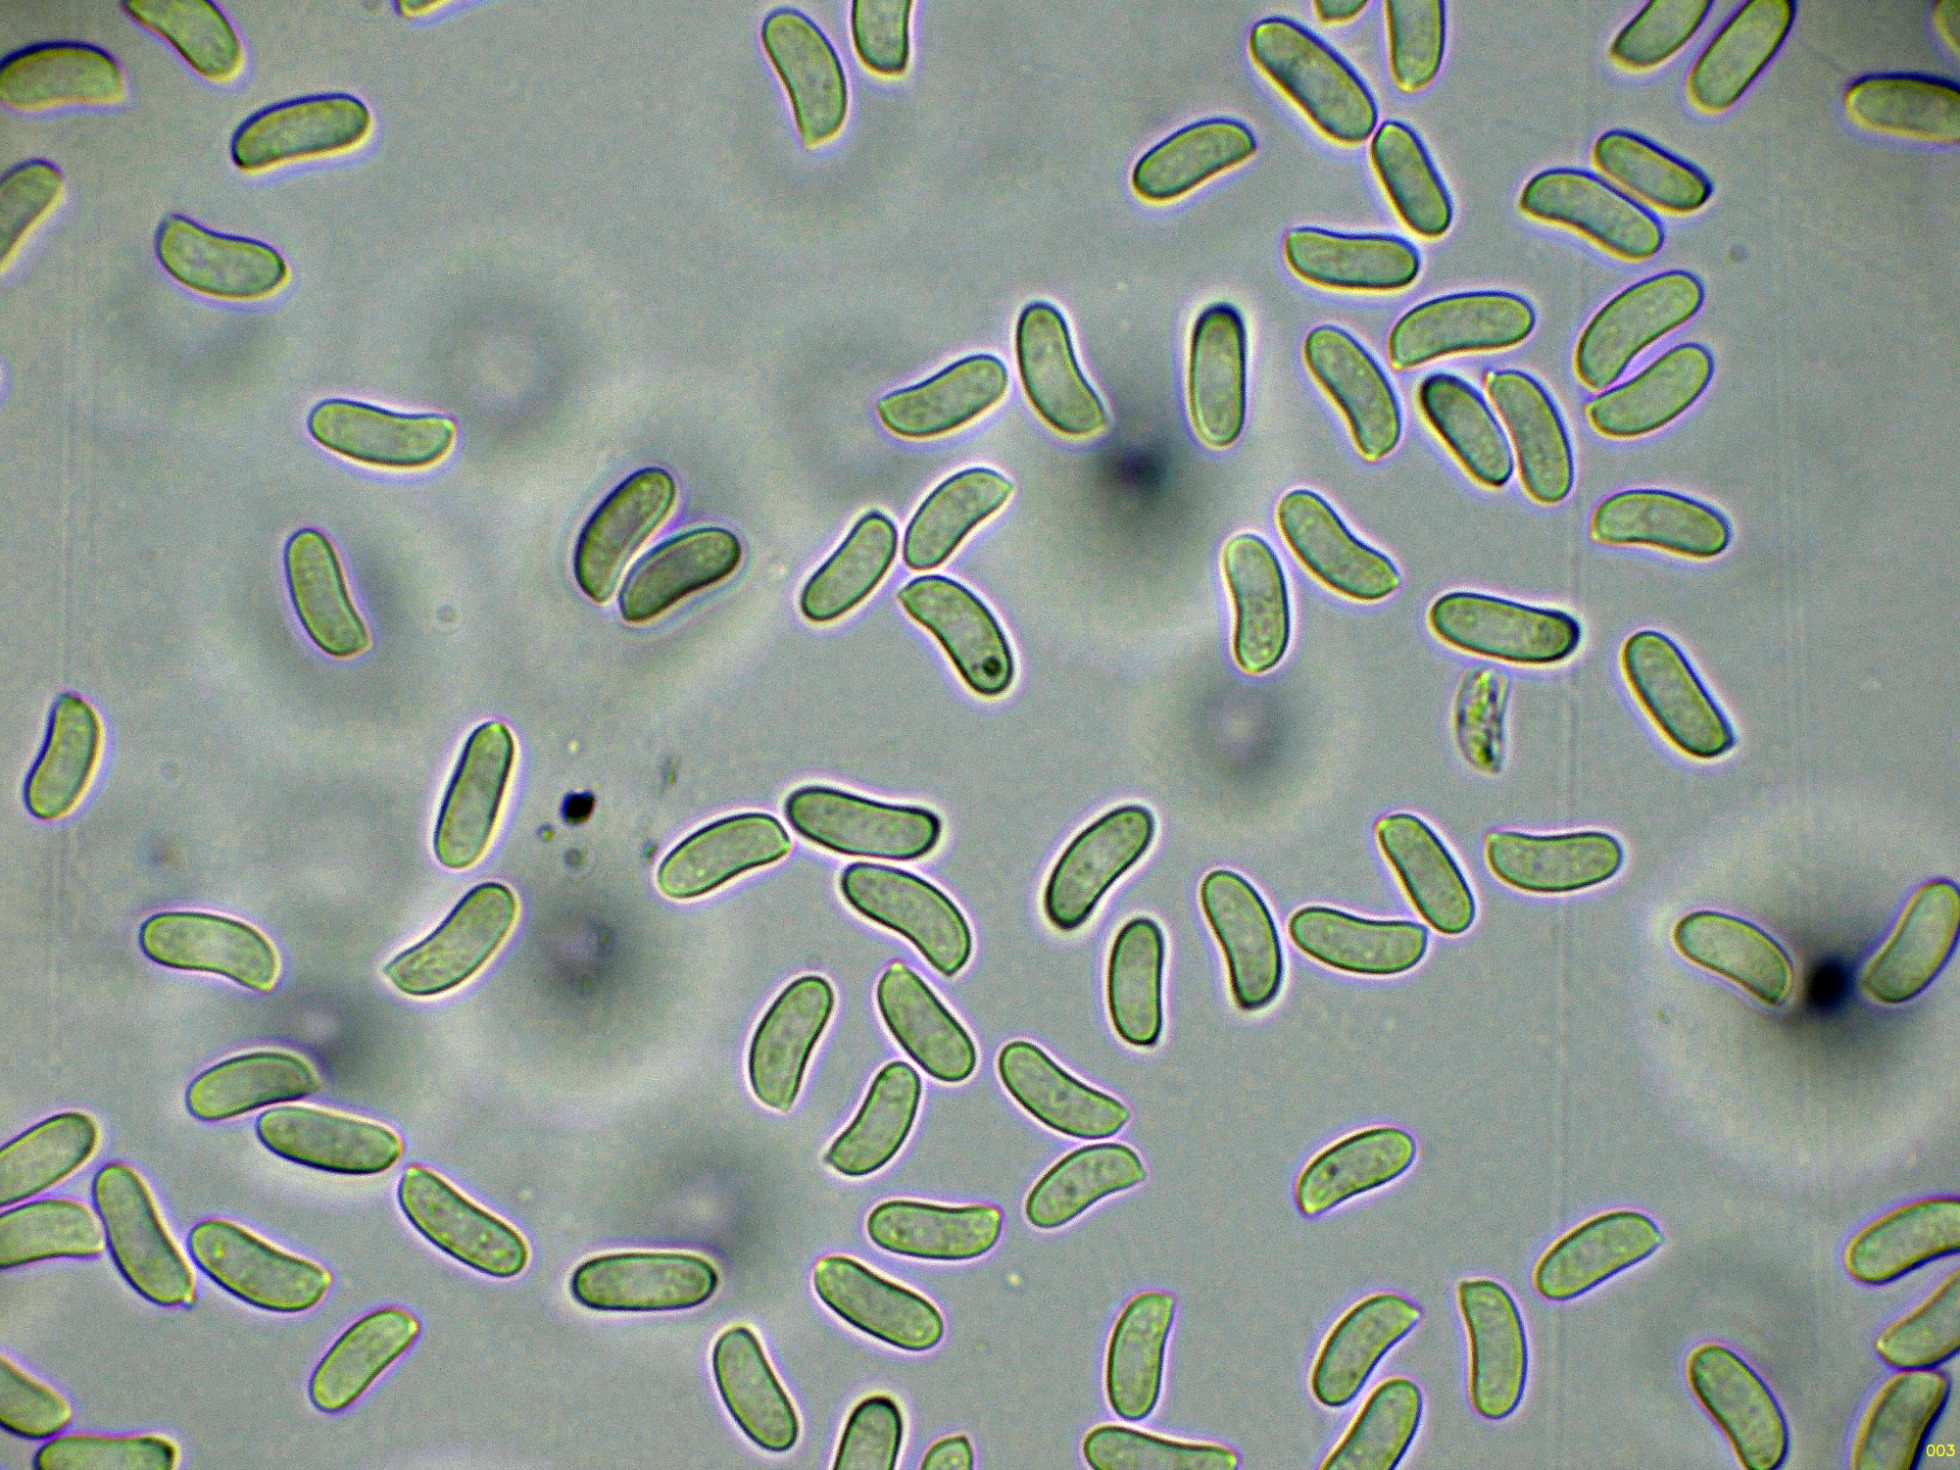

- Foro
- Foros sobre Micología de fungipedia
- Microscopía
- Media docena y alguna cosa más del domingo 6 de abril.
 Media docena y alguna cosa más del domingo 6 de abril.
Media docena y alguna cosa más del domingo 6 de abril.
- Josep Torres
-
 Autor del tema
Autor del tema
- Fuera de línea
- Moderador
-

Menos
Más
- Mensajes: 8746
- Gracias recibidas: 8379
11 meses 4 semanas antes - 11 meses 4 semanas antes #110509
por Josep Torres
Hola.
Unos hongos recolectados el domingo 6 de abril pasado, todos ellos pertenecientes a especies que ya había estudiado con anterioridad.
El primero una Nectriaceae brotando sobre un pequeño tronco del suelo, este es solo la segunda vez que me lo encuentro, brotando entre una buena masa de Ozonium de Coprinus sp., la Dialonectria episphaeria.
En este estudio pude obtener una buena cantidad de esporas, la suficiente como para poder observar su color asalmonado.
Los ascomas a 20 aumentos:
Un par de imágenes de estos ascomas a 40 aumentos:
Las hifas del peridio externo en agua:
Las hifas del peridio en solución de Azul de Lactofenol:
Las mismas hifas en solución de KOH:
Los ascos a 400 aumentos en agua:
Ascos en agua a 1000 aumentos:
Los ascos en Azul de Lactofenol:
Y las esporas en agua:
Estas esporas obtenidas por esporulación natural y en agua con unas medidas de:
(6.8) 7.2 - 8.5 (9.9) × (3.3) 3.5 - 3.8 (4) µm
Q = (1.9) 2 - 2.4 (2.8) ; N = 40
Me = 7.9 × 3.6 µm ; Qe = 2.2
Seguimos con un basidiomiceto disfrazado de ascomiceto, este lo encontré el mismo día sobre dos sustratos completamente distintos, la Lachnella villosa:
Los basidiomas sobre un pequeño tronco de Rubus:
También sobre una hoja del suelo de Hedera helix:
Los ejemplares a 20 aumentos:
Un ejemplar a 40 aumentos:
Los pelos marginales a 400 aumentos en agua:
Los pelos en agua a 1000 aumentos:
Sus grandes basidios en agua:
En este caso aunque no pude obtener esporas, no me quedan dudas en cuanto a su identidad.
Sobre unos tallos de gramíneas en descomposición tenemos el Lophodermium gramineum:
Los ascomas a 20 aumentos:
Ascomas a 40 aumentos:
Los ascos en solución de Rojo Congo:
Los ascos en agua:
Y una composición de las pocas esporas libres observadas:
Estas esporas libres con unas medidas de 29.2 - 37.3 × 1.5 - 1.9 µm.
Seguimos.......................................................
Unos hongos recolectados el domingo 6 de abril pasado, todos ellos pertenecientes a especies que ya había estudiado con anterioridad.
El primero una Nectriaceae brotando sobre un pequeño tronco del suelo, este es solo la segunda vez que me lo encuentro, brotando entre una buena masa de Ozonium de Coprinus sp., la Dialonectria episphaeria.
En este estudio pude obtener una buena cantidad de esporas, la suficiente como para poder observar su color asalmonado.
Los ascomas a 20 aumentos:
Un par de imágenes de estos ascomas a 40 aumentos:
Las hifas del peridio externo en agua:
Las hifas del peridio en solución de Azul de Lactofenol:
Las mismas hifas en solución de KOH:
Los ascos a 400 aumentos en agua:
Ascos en agua a 1000 aumentos:
Los ascos en Azul de Lactofenol:
Y las esporas en agua:
Estas esporas obtenidas por esporulación natural y en agua con unas medidas de:
(6.8) 7.2 - 8.5 (9.9) × (3.3) 3.5 - 3.8 (4) µm
Q = (1.9) 2 - 2.4 (2.8) ; N = 40
Me = 7.9 × 3.6 µm ; Qe = 2.2
Seguimos con un basidiomiceto disfrazado de ascomiceto, este lo encontré el mismo día sobre dos sustratos completamente distintos, la Lachnella villosa:
Los basidiomas sobre un pequeño tronco de Rubus:
También sobre una hoja del suelo de Hedera helix:
Los ejemplares a 20 aumentos:
Un ejemplar a 40 aumentos:
Los pelos marginales a 400 aumentos en agua:
Los pelos en agua a 1000 aumentos:
Sus grandes basidios en agua:
En este caso aunque no pude obtener esporas, no me quedan dudas en cuanto a su identidad.
Sobre unos tallos de gramíneas en descomposición tenemos el Lophodermium gramineum:
Los ascomas a 20 aumentos:
Ascomas a 40 aumentos:
Los ascos en solución de Rojo Congo:
Los ascos en agua:
Y una composición de las pocas esporas libres observadas:
Estas esporas libres con unas medidas de 29.2 - 37.3 × 1.5 - 1.9 µm.
Seguimos.......................................................
Adjuntos:
Última Edición: 11 meses 4 semanas antes por Josep Torres. Razón: Una falta de ortografía.
Por favor, Identificarse para unirse a la conversación.
- Josep Torres
-
 Autor del tema
Autor del tema
- Fuera de línea
- Moderador
-

Menos
Más
- Mensajes: 8746
- Gracias recibidas: 8379
11 meses 4 semanas antes - 11 meses 4 semanas antes #110510
por Josep Torres
Respuesta de Josep Torres sobre el tema Media docena y alguna cosa más del domingo 6 de abril.
Sobre la superficie de un pequeño tronco del suelo tenemos el Hysterographium fraxini:
Los abundantes ascomas a 20 aumentos:
Y unas imágenes de los ascos con sus esporas moriformes en su interior:
Una Peniophora, en mi opinión la más abundante en soto fluvial, por lo menos por mi zona, la Peniophora lycii:
Superficie del basidioma a 20 aumentos:
Los cistidios en solución de Rojo Congo:
Los dendrohifidios:
Los basidios:
Y las esporas en agua:
Estas esporas obtenidas por esporulación natural y en agua con unas medidas de:
(8.9) 9.4 - 10.6 (10.9) × (3.7) 3.8 - 4.1 (4.3) µm
Q = (2.3) 2.4 - 2.6 (2.8) ; N = 30
Me = 10 × 4 µm ; Qe = 2.5
También un Mixomiceto, este por sus características, su identidad no ofrece confusión alguna, el Dictydiaethalium plumbeum.
Un par de imágenes de su superficie a 20 aumentos:
La sección a 100 aumentos:
Capilicio y esporas a 400 aumentos:
Y por último las esporas a 1000 aumentos:
Añado unas imágenes de un par de cosillas que se dejaron ver este mismo día, ambas de especies ya más parecidas a lo que consideramos como setas, por un lado la Cyclocybe aegerita = Cyclocybe cylindracea:
Y por otro lado brotando además de manera abundante, el Polyporus arcularius, actualmente Lentinus arcularius.
Saludos.
Los abundantes ascomas a 20 aumentos:
Y unas imágenes de los ascos con sus esporas moriformes en su interior:
Una Peniophora, en mi opinión la más abundante en soto fluvial, por lo menos por mi zona, la Peniophora lycii:
Superficie del basidioma a 20 aumentos:
Los cistidios en solución de Rojo Congo:
Los dendrohifidios:
Los basidios:
Y las esporas en agua:
Estas esporas obtenidas por esporulación natural y en agua con unas medidas de:
(8.9) 9.4 - 10.6 (10.9) × (3.7) 3.8 - 4.1 (4.3) µm
Q = (2.3) 2.4 - 2.6 (2.8) ; N = 30
Me = 10 × 4 µm ; Qe = 2.5
También un Mixomiceto, este por sus características, su identidad no ofrece confusión alguna, el Dictydiaethalium plumbeum.
Un par de imágenes de su superficie a 20 aumentos:
La sección a 100 aumentos:
Capilicio y esporas a 400 aumentos:
Y por último las esporas a 1000 aumentos:
Añado unas imágenes de un par de cosillas que se dejaron ver este mismo día, ambas de especies ya más parecidas a lo que consideramos como setas, por un lado la Cyclocybe aegerita = Cyclocybe cylindracea:
Y por otro lado brotando además de manera abundante, el Polyporus arcularius, actualmente Lentinus arcularius.
Saludos.
Adjuntos:
Última Edición: 11 meses 4 semanas antes por Josep Torres. Razón: Poner 2 nombres en negrita.
El siguiente usuario dijo gracias: Juan Andrés Román
Por favor, Identificarse para unirse a la conversación.
- Foro
- Foros sobre Micología de fungipedia
- Microscopía
- Media docena y alguna cosa más del domingo 6 de abril.
Tiempo de carga de la página: 0.649 segundos

Foro de micología